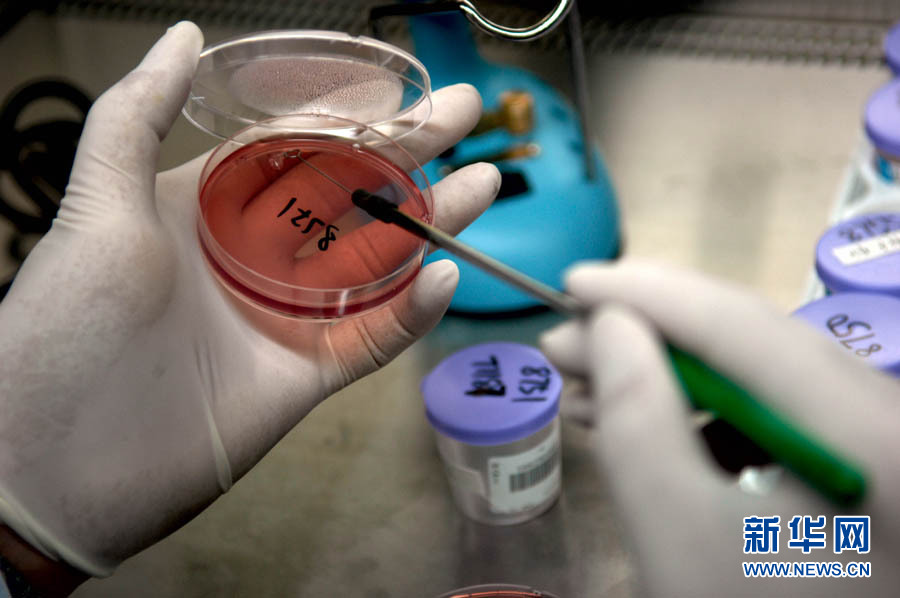
探访超级细菌实验室(高清组图)

细菌实验

探访超级细菌实验室(高清组图)
图片尺寸900x598
微生物实验室中科学家实验室技术员接种环培养板细菌接种研究
图片尺寸700x467
兴济镇港西学校二年级爱护卫生细菌观察实验
图片尺寸4032x3024![主题:【分享】探访超级细菌实验室[高清组图]](https://i.ecywang.com/upload/1/img0.baidu.com/it/u=1297662650,1226937060&fm=253&fmt=auto&app=138&f=JPEG?w=753&h=500)
主题:【分享】探访超级细菌实验室[高清组图]
图片尺寸900x598
显微镜下的革兰氏细菌@青岛特斯特 @趵突泉7 @实验室制作美 - 抖音
图片尺寸1706x1280
显微镜下细菌的研究.实验室科研照片
图片尺寸450x300
科学家在实验室研究病毒和细菌细胞培养皿
图片尺寸1280x850
细菌学图片
图片尺寸452x350
子木雅居生物显微镜标本观察切片套装动物植物细胞细菌实验儿童学生载
图片尺寸800x800
我爱洗手之——细菌培养皿小实验
图片尺寸1600x1066
2012级初二年级开展培养细菌真菌实验结论交流活动
图片尺寸830x300
大学生们匠心独运,借助微生物实验技术,以菌为翰墨,皿为宣纸,用细菌在
图片尺寸930x620
细菌培养实验
图片尺寸532x1202
显微镜下细菌的研究.实验室科研
图片尺寸700x467
研究人员正在实验室检测细菌
图片尺寸700x467
实验室的科研.显微镜下细菌的研究照片
图片尺寸450x300
细菌的分布——万融实验
图片尺寸640x618
学病理学作为科学实验的一部分,科学家在培养皿中用琼脂凝胶培养细菌
图片尺寸450x300
家长走进课堂:让我们一起认识"它"——细菌
图片尺寸2133x1600
130家实验室想引进它的病毒细菌这口子上海敢不敢开
图片尺寸690x390



![主题:【分享】探访超级细菌实验室[高清组图]](https://i.ecywang.com/upload/1/img0.baidu.com/it/u=1297662650,1226937060&fm=253&fmt=auto&app=138&f=JPEG?w=753&h=500)

![主题:【分享】探访超级细菌实验室[高清组图]](https://img.ycwb.com/news/attachement/jpg/site2/20101030/90fba60187190e35b72d07.jpg)















